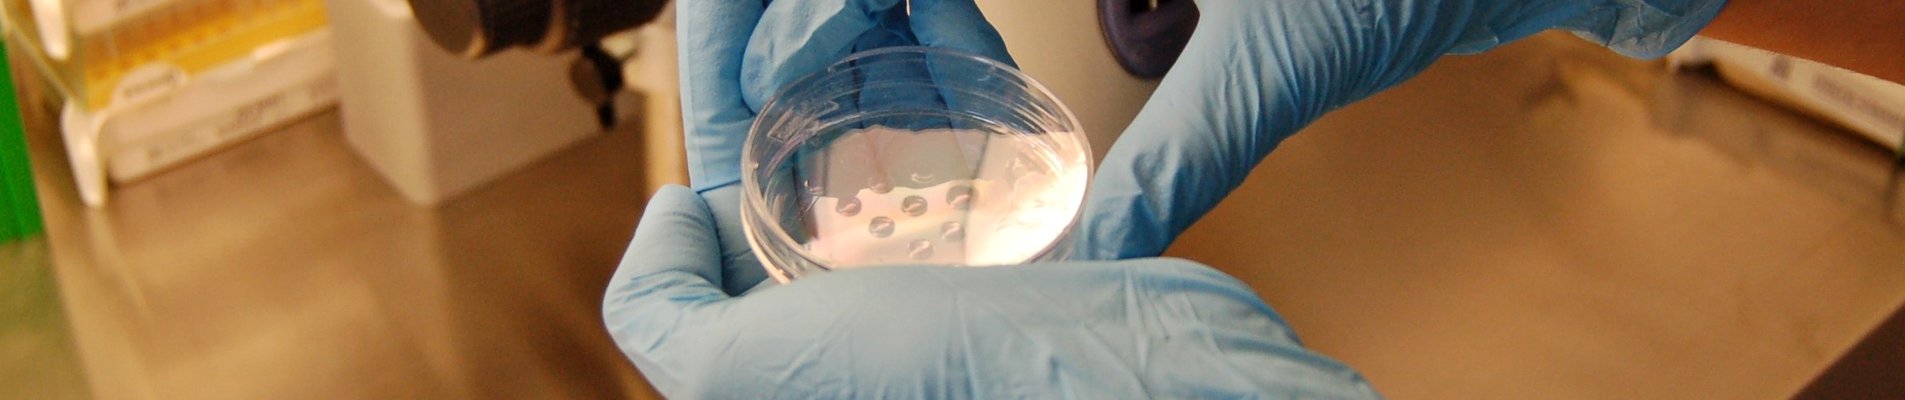

Фабрика за чудеса
 Място, на което се случват чудеса. Така описва своя бизнес д-р Методия Секуловски, управител на инвитро клиниката Неовитро. Желанието му е да създаде един „оазис“ за пациентите с репродуктивни проблеми.Той успява да изпълни мечтата си, а с нея – и мечтите на десетки семейства да се сдобият с най-големия дар: техните деца. Представяме ви фабриката за чудеса Неовитро, която се развива с подкрепата на ББР.
Място, на което се случват чудеса. Така описва своя бизнес д-р Методия Секуловски, управител на инвитро клиниката Неовитро. Желанието му е да създаде един „оазис“ за пациентите с репродуктивни проблеми.Той успява да изпълни мечтата си, а с нея – и мечтите на десетки семейства да се сдобият с най-големия дар: техните деца. Представяме ви фабриката за чудеса Неовитро, която се развива с подкрепата на ББР.
Знаете ли, че 1 от 6 души в световен мащаб е с репродуктивни проблеми? Данните са от доклад на Световната здравна организация, публикуван през април, който отбелязва, че около 17,5% от пълнолетното население среща затруднения в създаването на потомство. По последни данни над 290 хиляди двойки у нас имат репродуктивни проблеми. За съжаление този брой се увеличава всяка година, посочват от „Неовитро“. Причините са много, като голяма част от тях са свързани с генетични и имунологични проблеми, съвременния начин на живот, стрес, хранене, алкохол, тютюнопушене и др.
„Ние лекуваме пациенти с тежки репродуктивни проблеми. Над 80% от пациентите ни са двойки с проблеми, продължаващи повече от 5 години, както и такива, които са се лекували в различни клиники в България, Турция и Европа“, споделя д-р Секуловски. И допълва, че у нас все още не се обръща достатъчно внимание на профилактиката на здравето, което може да доведе до задълбочаване на редица проблеми. Поради тази причина в центъра се организират безплатни прегледи и консултации с експерти, които да окажат подкрепа и насоки на двойките с репродуктивни затруднения.
Усилията явно дават резултат, защото въпреки че работи едва от три години, благодарение на специалистите в Неовитро вече са се родили 56 бебета. А още 20 бременни пациентки очакват своите чудеса съвсем скоро. Броят на извършените инвитро процедури е 400, което нарежда Неовитро
сред клиниките с най-висока успеваемост
в страната. Центърът разполага с модерни инвитро, андрологична и крио лаборатории, които са оборудвани с най-съвременна техника за изпълнение на специфичните процедури. Освен специалисти по акушерство, гинекология и репродуктивна медицина, тук има и капацитети по ембриология, андрология, репродуктивна имунология, ендокринология, хематология, хранене и диететика и други медицински области. „За нас екипната работа е в основата на успеха. Имаме персонализиран подход към пациентите“, споделя д-р Секуловски.
Неовитро е една от малкото клиники в България, които извършват дейности по асистирана репродукция на спонтанен (естествен) цикъл. Изключително важна е и преимплантационната генетичнa диагностика, чрез която могат да се предотвратят наследствени заболявания. Тестовете се фокусират само върху информацията от медицинско значение, имаща отношение към живота и здравето на детето, което ще се роди. Информация за фенотипа като цвят на очи, коса, височина и др. би могла да бъде получена при специално конструиране на теста, но не и в рутинните пациентски тестове, уточнява управителят на инвитро центъра.
Отскоро Неовитро предлага и изследвания, свързани с човешкия геном при репродуктивни проблеми. „Идеята ни е
да създадем собствена генетична лаборатория
за по-бърза диагностика и лечение на проблемите, свързани с репродукцията“, казва д-р Секуловски.
В тази посока е и инвестицията от Българската банка за развитие – средствата са оползотворени за реновиране и изграждане на материалната база на Медицинския център, както и закупуване на апаратура за внедряване на модерни технологии и съвременни методики, за извършване на учебна и научна дейност в областта на асистираната репродукция.
А нашият екип вярва, че благодарение на тях ще се случат още много чудеса.
